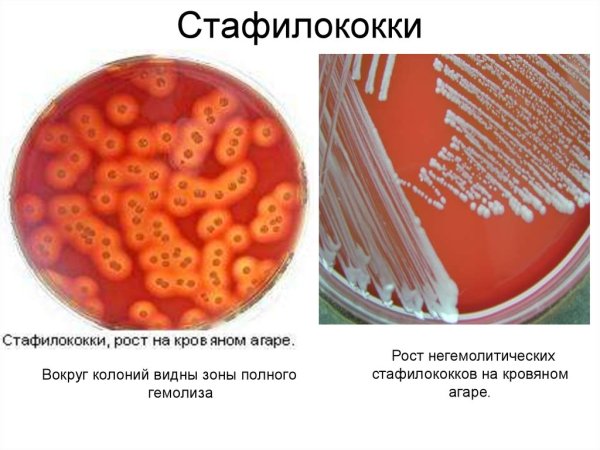
Культуральные Staphylococcus aureus на кровяном агаре
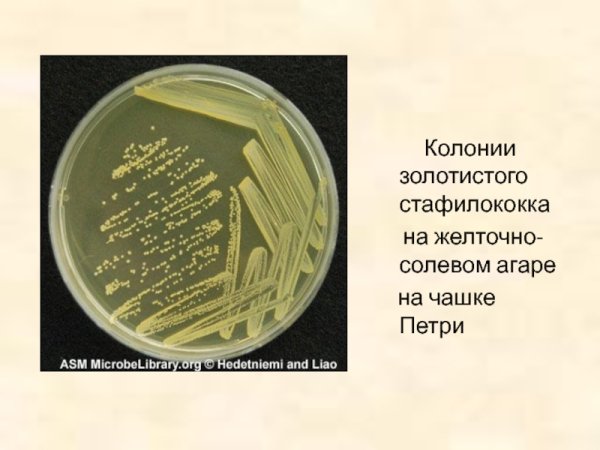
Стафилококкус ауреус
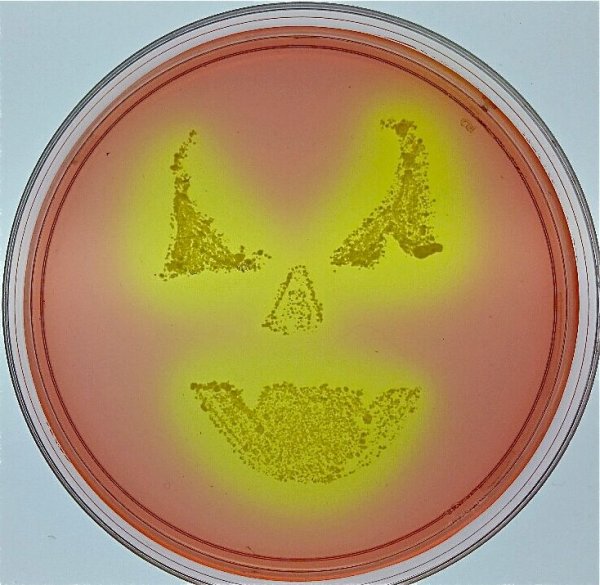
Стафилококки стрептококки кишечная палочка
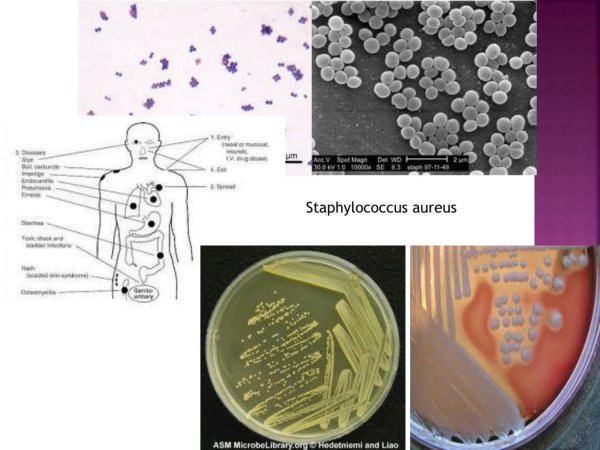
Сарцины бактерии
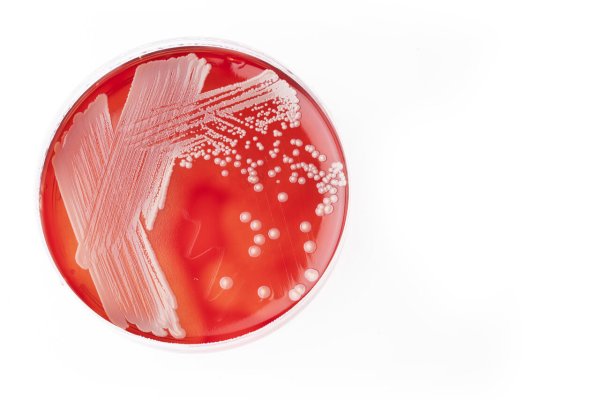
Стафилококки стрептококки кишечная палочка
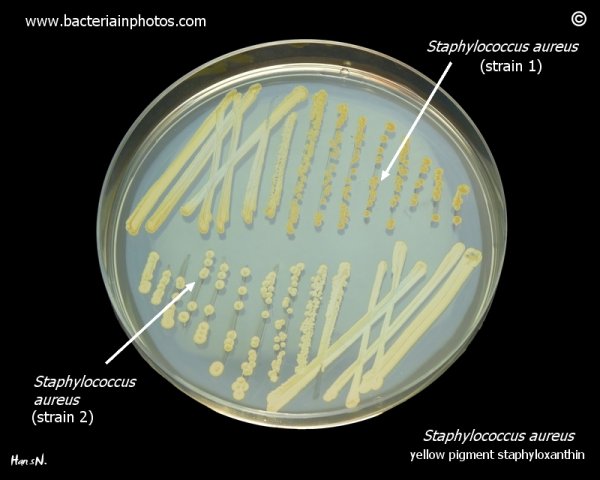
Золотистый стафилококк культуральные свойства
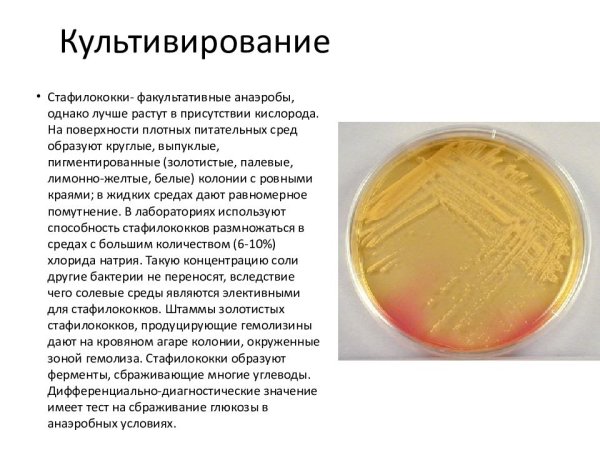
Стафилококки рисунок

Золотистый стафилококк - это микроорганизм, принадлежащий к группе стафилококков, которые характеризуются золотистым оттенком на питательных средах. Эти бактерии имеют сферическую форму и часто формируют колонии в виде густых кластеров. Золотистый стафилококк является одним из наиболее распространенных патогенных микроорганизмов для человека, вызывая различные инфекционные заболевания, такие как пиодермия, пневмония, сепсис и другие. Он обладает способностью выделять токсины и энзимы, которые способствуют его патогенности. Учитывая его патогенный потенциал, золотистый стафилококк требует серьезного внимания и контроля, особенно в медицинских учреждениях и пищевой промышленности.
Стафилококк рисунок микробиология
Стафилококки окраска генцианвиолет
Стафилококки рисунок
Культуральные Staphylococcus aureus на кровяном агаре
Стафилококки микробиология морфология
Коагулазопозитивные стафилококки
Кокки стрептококки
S. aureus иллюстрация
Стафилококки генцианвиолет
Золотистый стафилококк сообщение 5 класс
Бактерия стафилококк Тип питания
Хламидия микробиология мазок
Строение бактерии стафилококка
Борьба с микробами
Золотистый стафилококк рисунок микробиология
Золотистый стафилококк кратко
Желточно-солевой агар (ЖСА)
Стафилококкус ауреус
Стафилококки стрептококки кишечная палочка
Пневмококки форма бактерии
Пневмококк золотистый стафилококк
Палочки кокки
Стафилококки располагаются
Мазок чистой культуры s aureus
Стафилококк в организме человека
Сарцины бактерии
Стафилококки представители
Стафилококк строение
Кишечная палочка и золотистый стафилококк
Стафилококки стрептококки кишечная палочка
Стафилококк на белом фоне
Стафилококки спорообразующие
Бемории стафилококки
Золотистый стафилококк культуральные свойства
Стафилококки рисунок
Гемокультура золотистый стафилококк
Стафилококк золотистый Staphylococcus aureus
Сыпь атопического дерматита
Бактерии стафилококки
Бактерия золотистый стафилококк
Бактерии стафилококки
Смотрите онлайн или можете скачать на телефон или компьютер в хорошем качестве совешенно бесплатно. Не забывайте оставить комментарий и посмотреть другие фотографии и изображения высокого качества, например рисунок поцелуй воздушный и рисунок белые цветы из раздела Рисунки

Grizly.club
Grizly.club